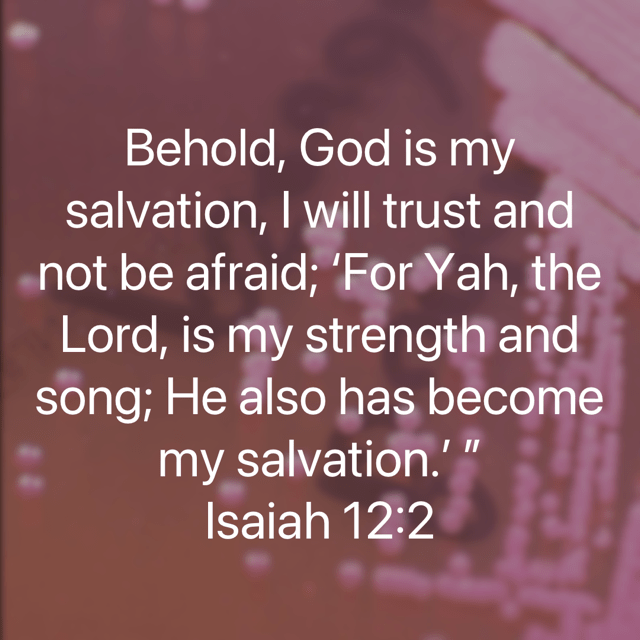
Isaiah 12:2 NKJV
The background is Burkholderia pseudomallei on Ashdown media. The photograph was shot by Dr Gary Lum at Royal Darwin Hospital.
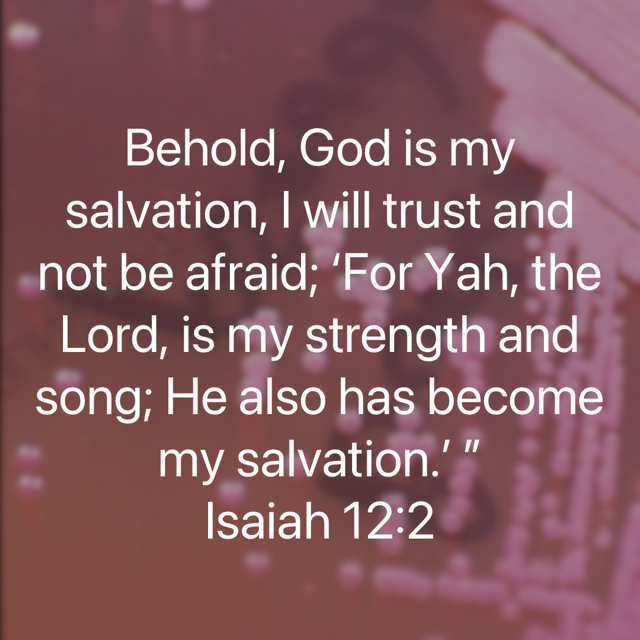

Commentary on Isaiah 12:2
Text (NKJV):
“Behold, God is my salvation, I will trust and not be afraid; For YAH, the LORD, is my strength and song; He also has become my salvation.”
1. Context of Isaiah 12
Isaiah 12[i] is a short but profound hymn of praise that concludes the section beginning in Isaiah 7–11. These chapters deal with God’s promises of deliverance, the coming of the Messiah, and the establishment of His righteous reign. Chapter 12 functions as a doxology, a response of worship to God’s saving acts. It is structured as two songs (verses 1–3 and verses 4–6), both celebrating God’s salvation and inviting His people to trust and rejoice in Him.
2. Exegesis of Isaiah 12:2
- “Behold, God is my salvation”
The declaration is deeply personal. Salvation is not merely a gift from God but is identified with God Himself. This anticipates the New Testament revelation that salvation is found in Christ alone (John 14:6 [Jesus said to him, “I am the way, the truth, and the life. No one comes to the Father except through Me.]; Acts 4:12 [Nor is there salvation in any other, for there is no other name under heaven given among men by which we must be saved.”]). The believer’s confidence rests not in human effort but in God’s gracious initiative. - “I will trust and not be afraid”
Trust in God displaces fear. In Isaiah’s context, Judah faced political threats and instability. Yet the prophet calls the people to faith rather than fear. This resonates with the Christian emphasis on faith as resting in God’s promises, not in human strength. Fear is overcome by confidence in God’s sovereignty. - “For YAH, the LORD, is my strength and song”
The use of “YAH” (a shortened form of Yahweh) highlights intimacy and covenant relationship. God is both strength (empowering His people) and song (the source of joy and worship). This echoes Exodus 15:2 [The Lord is my strength and song, And He has become my salvation; He is my God, and I will praise Him; My father’s God, and I will exalt Him.], where Israel sang after deliverance from Egypt. Salvation leads naturally to worship. - “He also has become my salvation”
Salvation is not abstract but experiential. God Himself acts to save, and His people experience that salvation personally. In Christian theology, this points to the doctrine of union with Christ: salvation is not merely something Christ gives but is found in Christ Himself.
3. Theological Teaching
- God-centred salvation: Salvation is not earned but received. God Himself is salvation, reminding us of the monergistic nature of redemption.
- Faith over fear: Trust in God is the antidote to fear. This reflects the Christian conviction that faith is a gift of God, enabling believers to rest in His promises.
- Worship as response: Salvation leads to song. True theology always leads to doxology. Worship is the natural overflow of experiencing God’s saving grace.
- Christological fulfilment: Isaiah 12:2 finds its fullest expression in Jesus Christ, who embodies God’s salvation. The believer’s strength and song are found in Him.
4. Application to Modern Christian Living
- Personal assurance: Christians today can echo Isaiah’s words, affirming that God Himself is their salvation. This provides assurance in a world of uncertainty.
- Courage in adversity: Trusting God enables believers to face challenges without fear. Whether in personal trials or societal pressures, faith in God’s sovereignty steadies the heart.
- Joyful worship: Salvation should lead to joyful praise. Christians, often living in a secular environment, can bear witness by singing God’s praises with gladness and confidence.
- Christ-centred living: Believers are called to live with Christ as their strength and song, drawing daily power and joy from Him.
[i] Isaiah 12
New King James Version
A Hymn of Praise
12 And in that day you will say:
“O Lord, I will praise You;
Though You were angry with me,
Your anger is turned away, and You comfort me.
2 Behold, God is my salvation,
I will trust and not be afraid;
‘For Yah, the Lord, is my strength and song;
He also has become my salvation.’ ”
3 Therefore with joy you will draw water
From the wells of salvation.
4 And in that day you will say:
“Praise the Lord, call upon His name;
Declare His deeds among the peoples,
Make mention that His name is exalted.
5 Sing to the Lord,
For He has done excellent things;
This is known in all the earth.
6 Cry out and shout, O inhabitant of Zion,
For great is the Holy One of Israel in your midst!”
Discover more from Daily bible verses
Subscribe to get the latest posts sent to your email.

You must be logged in to post a comment.